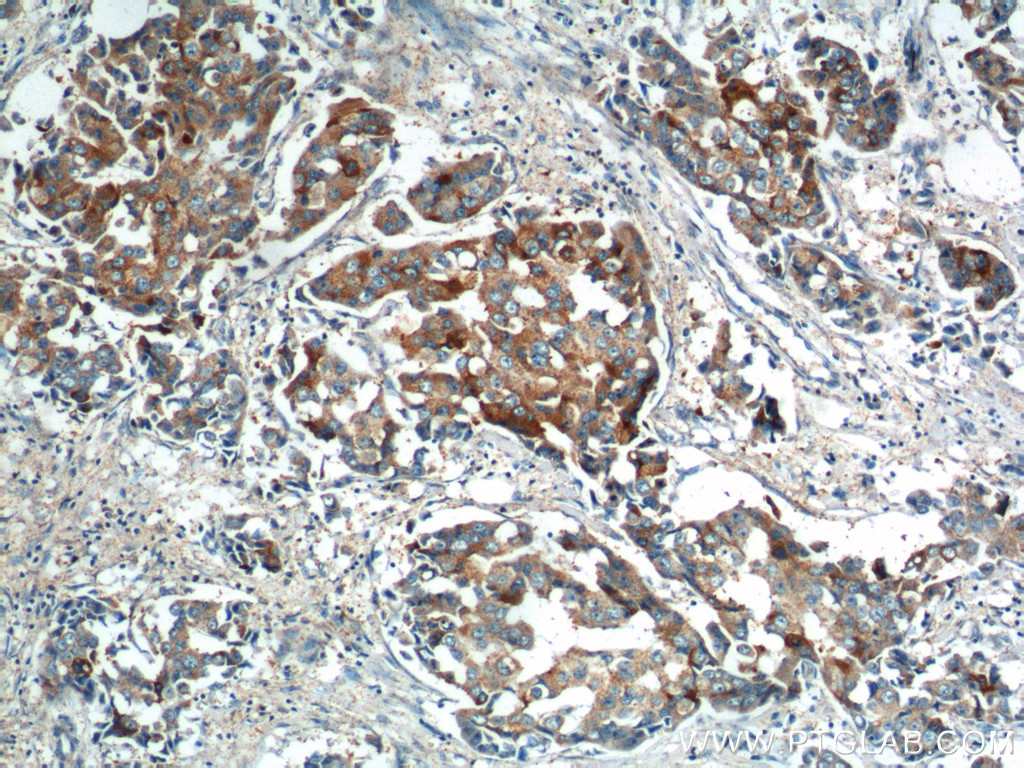

PRELID1抗体
产品名称: PRELID1抗体
英文名称: PRELID1Antibody
产品编号: XY10877-1
产品价格: null
产品产地: 中国/美国
品牌商标: XYbscience
更新时间: 2023-08-17T09:55:27
使用范围: WB,ELISA,IHC-P,IHC-F,IF
- 联系人 : 徐经理
- 地址 : 上海市闵行莘庄工业区春东路508号A1-2F
- 邮编 : 200612
- 所在区域 : 上海
- 电话 : 152****8802 点击查看
- 传真 : 点击查看
- 邮箱 : shxysw02@163.com
- 二维码 : 点击查看
PRELID1抗体Applications
IP = Immunoprecipitation
XY966Hu21 干扰素α21(IFNα21)单克隆抗体 Monoclonal Antibody to Interferon Alpha 21 (IFNa21) Homo sapiens (Hukl)
XY970Ra21 干扰素α13(IFNα13)单克隆抗体 Monoclonal Antibody to Interferon Alpha 13 (IFNa13) Rattus norvegicus (Rat)
XY971Hu21 干扰素α10(IFNα10)单克隆抗体 Monoclonal Antibody to Interferon Alpha 10 (IFNa10) Homo sapiens (Hukl)
XY981Hu21 谷氧还蛋白(GLRX)单克隆抗体 Monoclonal Antibody to Glutaredoxin (GLRX) Homo sapiens (Hukl)
XY006Hu21 丙糖磷酸异构酶1(TPI1)单克隆抗体 Monoclonal Antibody to Triosephosphate Isomerase 1 (TPI1) Homo sapiens (Hukl)
XY009Hu21 肿瘤蛋白p53结合蛋白1(TP53BP1)单克隆抗体 Monoclonal Antibody to Tumor Protein p53 Binding Protein 1 (TP53BP1) Homo sapiens (Hukl)
XY015Hu21 踝蛋白2(TLN2)单克隆抗体 Monoclonal Antibody to Talin 2 (TLN2) Homo sapiens (Hukl)
XY018Hu21 转酮醇酶样蛋白1(TKTL1)单克隆抗体 Monoclonal Antibody to Transketolase Like Protein 1 (TKTL1) Homo sapiens (Hukl)
XY019Hu21 转酮醇酶(TKT)单克隆抗体 Monoclonal Antibody to Transketolase (TKT) Homo sapiens (Hukl)
XY019Ra21 转酮醇酶(TKT)单克隆抗体 Monoclonal Antibody to Transketolase (TKT) Rattus norvegicus (Rat)
XY022Hu21 Toll样受体衔接分子1(TICAM1)单克隆抗体 Monoclonal Antibody to Toll Like Receptor Adaptor Molecule 1 (TICAM1) Homo sapiens (Hukl)
XY027Hu21 Thimet脱寡肽酶1(THOP1)单克隆抗体 Monoclonal Antibody to Thimet Oligopeptidase 1 (THOP1) Homo sapiens (Hukl)
XY031Hu21 前列腺转谷氨酰胺酶(TGM4)单克隆抗体 Monoclonal Antibody to Transglutaminase 4, Prostate (TGM4) Homo sapiens (Hukl)
XY033Hu21 转谷氨酰胺酶6(TGM6)单克隆抗体 Monoclonal Antibody to Transglutaminase 6 (TGM6) Homo sapiens (Hukl)
XY035Hu21 反式高尔基体网状结构蛋白2(TGOLN2)单克隆抗体 Monoclonal Antibody to Trans Golgi Network Protein 2 (TGOLN2) Homo sapiens (Hukl)
XY050Hu21 线粒体转录因子A(TFAM)单克隆抗体 Monoclonal Antibody to Transcription Factor A, Mitochondrial (TFAM) Homo sapiens (Hukl)
XY053Hu21 胸苷嘧啶DNA糖基化酶(TDG)单克隆抗体 Monoclonal Antibody to Thymine DNA Glycosylase (TDG) Homo sapiens (Hukl)
XY061Hu21 TANK结合激酶1(TBK1)单克隆抗体 Monoclonal Antibody to TANK Binding Kinase 1 (TBK1) Homo sapiens (Hukl)